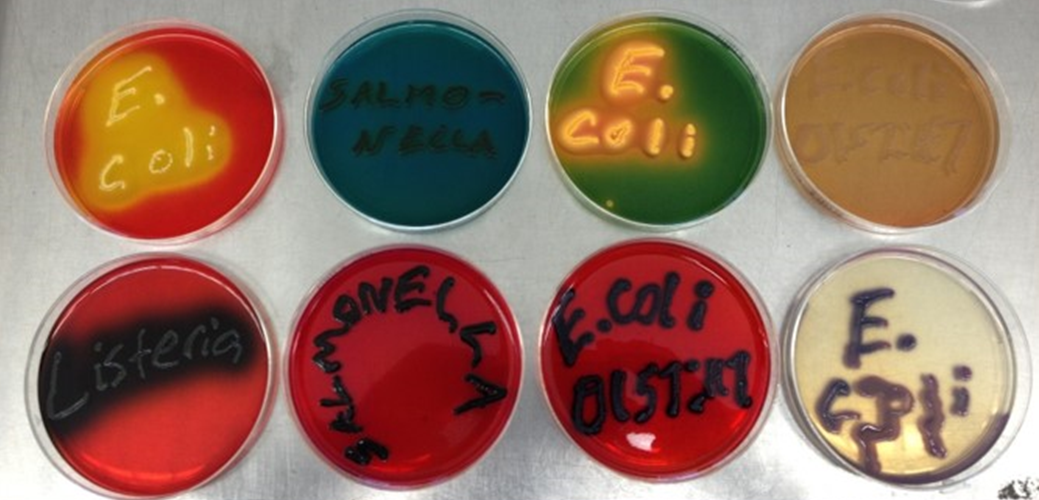
Eight petri dishes with different color agar media in each. Confluent bacterial growth on each  plate spells out the genus or species growing in each plate: E. coli, Salmonella, E. coli O157:H7 and Listeria

Clinical Bacteriology Group
Clinical Bacteriology Home | Clinical Bacteriology Testing at DSHS| Submitting Clinical Bacteriology Specimens to DSHS Laboratory | Clinical Bacteriology FAQs | Clinical Bacteriology Resources
Five differential and selective growth media were used to identify and isolate Escherichia coli and Salmonella spp. © DSHS 2022
What We Do
The Clinical Bacteriology Group identifies bacteria from clinical specimens and pure isolates using several methods, including:
- matrix-assisted laser desorption ionization time-of-flight mass spectrometry (MALDI-TOF),
- conventional biochemicals,
- phenotypic methods,
- commercial test kits,
- gas-liquid chromatography, and
- serogrouping or serotyping.
The identification and/or confirmation of pure cultures for the following organisms are carried out by the Clinical Bacteriology Group:
- Gram-negative non-fermentative rods
- Gram-positive rods including coryneform and Bacillus
- Gram-positive cocci including Streptococcus and Staphylococcus
- Enterobacteriaceae, Haemophilus, and Neisseria
The Laboratory also tests specimens submitted under Texas Administrative Code Chapter 97. Required specimen submissions include:
- Corynebacterium diphtheriae isolates,
- Haemophilus influenzae isolates from normally sterile sites from children younger than 5 years old,
- Listeria monocytogenes isolates,
- Neisseria meningitidis isolates from normally sterile sites or purpuric lesions,
- Salmonella species isolates including specimens positive for Salmonella by culture-independent diagnostic testing (CIDT) methods,
- Shiga toxin-producing Escherichia coli (all E. coli O157:H7 isolates, and any E. coli isolates or specimens in which Shiga toxin activity has been demonstrated),
- Staphylococcus aureus isolates with a vancomycin MIC greater than 2 μg/mL (VISA and VRSA),
- Streptococcus pneumoniae isolates from normally sterile sites in children younger than five years old, and
- Vibrio species isolates including specimens positive for Vibrio by CIDT methods.
The Clinical Bacteriology Group also
- confirms or completes the findings of other laboratories that lack the resources to conduct specialized procedures on isolates of significance (reportable) to the DSHS, and
- provides the laboratory resources that are required in epidemiological surveillance studies.
How to Use This Guide
This specimen submission and shipping guidance is for healthcare providers and clinical and reference laboratories that submit specimens to the DSHS Austin Laboratory for testing, outbreak, or surveillance purposes.
The information may also be of interest to patients. Those who have health concerns or who seek to submit specimens for analysis are encouraged to discuss those concerns with their healthcare provider. DSHS laboratory staff cannot make treatment recommendations.
Click on the menu item to quickly navigate to the section of interest.
Notices
Austin Laboratory Correspondence and Bulletins
Microbiological Sciences Branch Notices
How to Contact the Clinical Bacteriology Lab
Call: 512-776-7582 or (888) 963-7111 x7582 toll-free
Fax: 512-776-7452